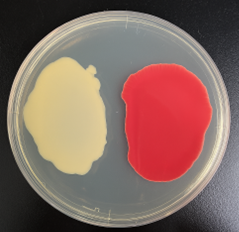
図2　スマートセル開発による菌体色の変化　左が改良前、右が改良後

スマートセルによる「リコピン」の大量生産技術を開発しました
―バイオものづくりで環境負荷低減と高機能素材の安定供給を両立―
2026年3月12日
NEDO(国立研究開発法人新エネルギー・産業技術総合開発機構)
NEDOの「カーボンリサイクル実現を加速するバイオ由来製品生産技術の開発」(以下、本事業)において、ハリマ化成株式会社と公益財団法人地球環境産業技術研究機構(RITE)は、狙った製品を高効率に生産するよう設計した細胞であるスマートセルを用い、化粧品・サプリメント・食品分野で需要が拡大している「リコピン」の大量生産技術の開発に成功しました。スマートセルによる発酵生産は、従来の植物抽出法や石油由来の合成法に比べ、二酸化炭素(CO2)排出量の削減に寄与するだけでなく、食料との競合を回避できる利点があります。このため、継続的な安定供給を可能とする製造プロセスとして期待されています。
本事業においては、すでに商用スケールでの培養実証を完了しており、2026年度内にスマートセルを用いたリコピンの一貫製造体制を構築し、商用展開を開始する計画です。

図1 スマートセルを活用したリコピン生産
1.背景
バイオものづくりは、遺伝子技術を活用して微生物や動植物などの細胞によって物質を生産することであり、従来の化学プロセスに比べて省エネルギーで、原料を非化石資源へ置き換えられることから、炭素循環型社会や持続的な経済成長に資する有力な選択肢として注目されています。一方で、石油由来製品と比較した場合、プロセスの複雑化や生産効率の制約により、価格競争力は低くなる傾向があります。
リコピンは、天然の赤色色素カロテノイドの一種で、抗酸化作用などの機能性を有し、化粧品・サプリメント・食品分野で需要が拡大しています。しかし、その製造にあたって、植物抽出法では季節や品種に起因する供給制約や品質変動が避けられず、石油由来の合成法では環境負荷が課題とされてきました。
こうした背景のもと、NEDOは2020年度から本事業※1で、バイオエコノミーの創出と炭素循環型社会の実現を目指して、バイオものづくりの基盤となる技術開発や生産実証拠点の構築、バイオ由来製品の実用化を目指す企業の実証テーマを推進してきました。その一環として2022年度から、ハリマ化成とRITEは協働して、スマートセルの活用によるリコピンの大量生産技術の構築を進めてきました。
2.今回の成果
本開発では、アミノ酸生産などで実績があり安全性の高いコリネ型細菌(Corynebacterium属)を宿主としたスマートセルを構築しました。RITEは、遺伝子組み換え技術によってリコピン生産に関連する生合成経路の強化に加え、副生物生産に関与する経路の遮断などの遺伝子工学的なアプローチにより、改良前の株と比較して100倍以上も生産性を向上させました。こうして単位培養液あたりグラム重量レベルでリコピンを生産する菌体の開発で事業化検証に資する生産量への到達に成功しました。
ハリマ化成は、菌体からリコピンを工業的に回収・精製するためのプロセス構築を進め、従来の植物抽出法や石油由来の合成法に比べ、CO2排出量の削減に寄与するだけでなく、食料との競合を回避できる利点も持った製造プロセスを開発しました。
スマートセルによる発酵菌体に対して高精度な精製工程を確立し、用途展開に適した高純度リコピン粉末を開発しました。本粉末はハンドリング性に優れ、夾雑物(きょうざつぶつ)が少ないことから、幅広い用途へ適用できます。
培養は、NEDO事業に参画するGreen Earth Institute株式会社(GEI)の関東圏バイオファウンドリ拠点の実証機能を活用し、3000L発酵槽でのスケールアップ実証に成功しました。
図2 スマートセル開発による菌体色の変化 左が改良前、右が改良後

図3 スケールアップ実証設備(3000L発酵槽)
3.今後の予定
カロテノイドは一般に体内吸収性(バイオアベイラビリティ)が低いことが課題とされています。ハリマ化成では、この課題に対し機能修飾工程を付与することで、バイオアベイラビリティを大きく向上させた高機能リコピンもラインアップに加え、製品展開を予定しています。これら高純度リコピンと高機能リコピンは化粧品市場で求められる各種安全性試験をクリアしており、今後は食品、医薬品グレードへの応用など、より幅広いニーズに応える製品展開を計画しています。
なお、機能性・有効性に関する最終的な表示は、各市場の関連法規・ガイドラインに準拠して実施します。
ハリマ化成は、本事業の成果で得たリコピン製品を順次市場展開し、素材がもつ有用性を生かした価値提供を進めていきます。2026年度内にサンプルワークを開始し、さらに商用生産開始を目指し、関連機関・企業との連携を強化していきます。
【注釈】
- ※1 本事業
- 事業名:カーボンリサイクル実現を加速するバイオ由来製品生産技術の開発
- 事業期間:2022年度~2024年度
- 事業概要:カーボンリサイクル実現を加速するバイオ由来製品生産技術の開発
- 参考:ハリマ化成リリース
- 当社初「高純度リコピンおよび高機能リコピン」の開発およびサンプル提供開始のお知らせ
4.問い合わせ先
(本ニュースリリースの内容についての問い合わせ先)
NEDO バイオ・材料部 スマートセルチーム 担当:小笠原、木下、大和田
TEL:044-520-5220 E-mail:bioproduction[*]ml.nedo.go.jp
(その他NEDO事業についての一般的な問い合わせ先)
NEDO 経営企画部 広報企画・報道課 TEL:044-520-5151 E-mail:nedo_press[*]ml.nedo.go.jp
E-mailは上記アドレスの[*]を@に変えて使用してください。
- ※新聞、TVなどで弊機構の名称をご紹介いただく際は、“NEDO(国立研究開発法人新エネルギー・産業技術総合開発機構)”または“NEDO”のご使用をお願いいたします。
関連ページ
- バイオものづくり
- 同分野のニュースリリースを探す
- 同分野の公募を探す
- 同分野のイベントを探す
